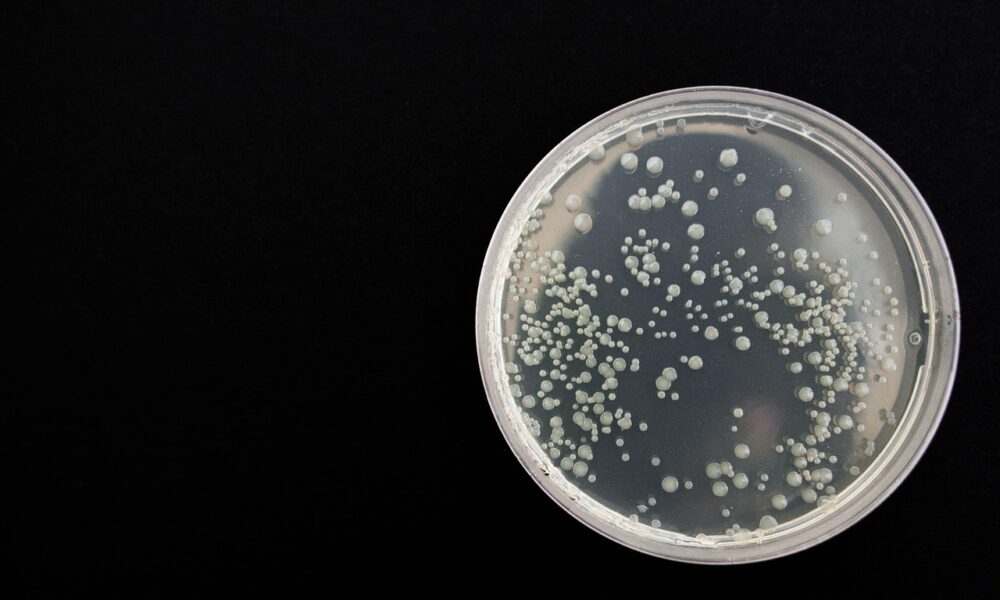

- Magyarország Legszebb Birtoka
- Közönségszavazás
- Támogatók
- Birtokbejárás 2025
- Videók
- Képek
- Korábbi győztesek
- Éves összefoglalók
- Magyarország Legszebb Birtoka 2017
- Magyarország Legszebb Birtoka 2018
- Magyarország Legszebb Birtoka 2019
- Magyarország Legszebb Birtoka 2020
- Magyarország Legszebb Birtoka 2021
- Magyarország Legszebb Birtoka 2022
- Magyarország Legszebb Birtoka 2023
- Magyarország Legszebb Birtoka 2024
- Birtokbejárárás 2024
- Magyarország Legszebb Birtoka
- Közönségszavazás
- Támogatók
- Birtokbejárás 2025
- Videók
- Képek
- Korábbi győztesek
- Éves összefoglalók
- Magyarország Legszebb Birtoka 2017
- Magyarország Legszebb Birtoka 2018
- Magyarország Legszebb Birtoka 2019
- Magyarország Legszebb Birtoka 2020
- Magyarország Legszebb Birtoka 2021
- Magyarország Legszebb Birtoka 2022
- Magyarország Legszebb Birtoka 2023
- Magyarország Legszebb Birtoka 2024
- Birtokbejárárás 2024